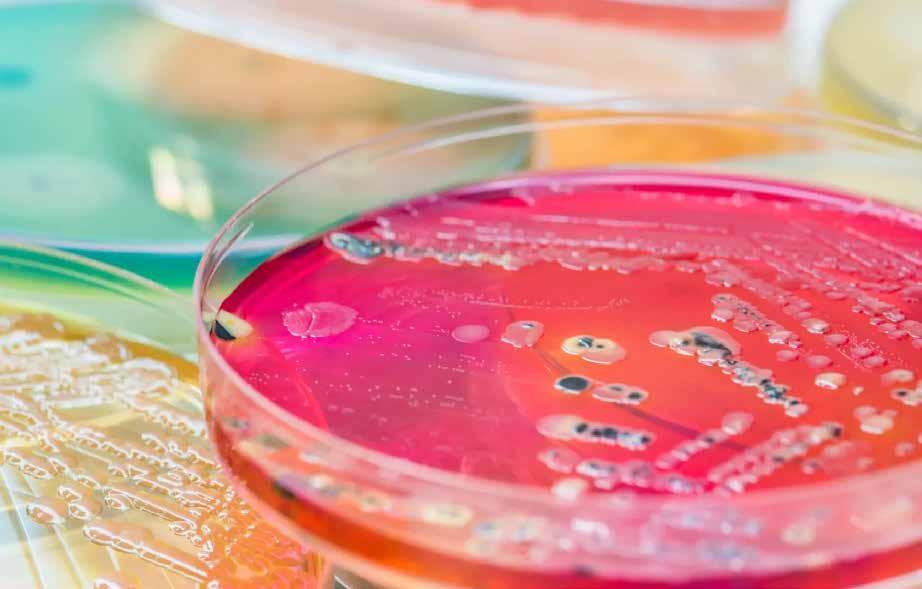

TUDOMÁNY ÉS KUTATÁS
A hiányzó oldalsó kismetszők részárással történő kezelése során a szemfogak és oldalsó fogak meziális mozgatása közben a fogszabályozó orvosnak csiszolással kell a fogak formáját igazítani. Már a kezelés elejétől a szemfog elcsiszolása nem csak az incizális részre...
IRÁNYVONALAK, ALKALMAZÁSOK
Az egyrészes kerámia implantátumok, a morfológiájuk miatt, pontos klinikai indikációkkal rendelkeznek a sikeres esztétikai és funkcionális rehabilitációhoz. Különösen a specifikus esetekben, a cirkónium implantátumok megfelelő, stabil működésű, kielégítő ellátási...
GYAKORLÓ FOGORVOS AJÁNLJA
Az elmúlt évtizedben a rögzített és az aligner fogszabályozás vált a kezelés standardjává. A fogak preparálásával és koronákkal járó nagyszabású mosolyátalakítások helyett a páciensek gyakran választják a konzervatívabb utat...
4. oldal 14. oldal 16. oldal
Nehéz poggyásszal indulunk 2023-ba Új-zélandi kutatók sikeres kísérletet folytattak a tű nélküli érzéstelenítéssel kapcsolatban
volt az első alkalom, hogy láttam valakit, aki jet-injekciót adott be egy karcsú pálcikán keresztül, amely egy kicsit olyan, mint egy három az egyben eszköz, és könnyen bevezethető a száj hátsó részébe.”
Katona József
Brendan Day, Dental Tribune International


A fogászati szorongás továbbra is jelentős akadálya a fogászati kezelésben részesülő pácienseknek, és a minimálisan invazív megközelítések egyre népszerűbbek. Az új-zélandi University of Otago, az Aucklandi Egyetem és az Aucklandi Műszaki Egyetem kutatóinak új együttműködése eredményeként egy olyan eszköz kipróbálására került sor, amely tű használata nélkül biztosítja a fogászati érzéstelenítést, és az eredmények ígéretesek.
Az elvi vizsgálatban nyolc résztvevő vett részt, akiknek a kezelési terv részeként kétoldali felső állcsonti foghúzásra volt szükségük. A résztvevők szorongási és kellemetlenségi szintjét a tű nélküli eszközzel történő érzéstelenítés és a hagyományos módszerrel történő érzéstelenítés előtt rögzítették. A tanulmány társszerzője, Andrew Taberner professzor, az Aucklandi Egyetem Aucklandi Biomérnöki Intézetének munkatársa szerint a csendes motorral működtetett eszköz egyedülálló abban a tekintetben, hogy kifejezetten fogászati felhasználásra tervezték, és nem más orvosi célokra adaptálták.
„Az összes többi fogászati jet-injektor rugót vagy sűrített gázt használ az injekció beadásához; ezeknek hátránya a zaj és a hatás, amikor a gyógyszert beadják” – nyilatkozta Taberner professzor a sajtóközleményben. „Ráadásul ez a tanulmány
A foghúzások elvégzése után minden páciens úgy nyilatkozott, hogy a tű nélküli érzéstelenítés beadása jobban tetszett neki, és a nyolc résztvevőből hatan úgy nyilatkoztak, hogy az ezzel az eszközzel végzett foghúzásuk fájdalommentes volt. A fennmaradó két résztvevőnek további, hagyományos módszerekkel alkalmazott érzéstelenítésre volt szüksége. A következő hét nap során a gyógyulást és az ínyszöveti reakciót a foghúzás helyén értékelték, és az alkalmazott technikától függetlenül eseménytelennek ítélték.
Prof. Paul Brunton, a tanulmány vezető szerzője és az Otagói Egyetem Egészségtudományi Részlegének rektorhelyettese kiemelte, hogy a fogászati szorongás továbbra is jelentős akadálya a fogászati ellátáshoz való hozzáférésnek, és hogy a félelem egyik gyakori oka „a tű látványa a helyi érzéstelenítés során”.

„Bár ez csak egy koncepciót igazoló kísérlet volt, ez az eszköz minden bizonnyal csökkentheti vagy megszüntetheti a tűfóbia miatti szorongást” – tette hozzá.
Tekintettel a vizsgálat kis méretére és korlátozott terjedelmére, klinikai vizsgálatokra lesz szükség a tű nélküli eszköz hatékonyságának validálásához és annak megerősítéséhez, hogy alkalmazható-e más fogászati eljárások során.

A „Jet injection needle-free dental anaesthesia: Initial findings” című tanulmányt a Journal of Dentistry 2022. júliusi számában tették közzé. DT

Bár már a nyár végére ígérték-remélték, végül karácsonyra készült el, s kapott szabad utat a Takács-csomag. Az új egészségügyi államtitkár, Takács Péter szakmai programját aggály nélkül támogatta a kormányzópárt parlamenti többsége, ennek ellenére az aligha hoz megnyugvást az ágazatban. Már csak azért sem, mert az elfogadott törvény eleve csupán keretet ad, amit további, alsóbb szintű jogszabályok töltenek majd ki konkrét megoldásokkal. Így a részletekben esetleg megbúvó „ördög” sem mutatkozhatott meg egyelőre. (A kapcsolódó rendeletek első adagjának megjelenése kevéssel lapzártánk után várható. Ugyancsak akkor kerülhet kormány elé a szakdolgozók 32/55 százalékos kétlépcsős béremeléséről szóló javaslat.) S azért sem várható megnyugvás az ágazatban, mert az igennel szavazó képviselők nem voltak tekintettel a szakmai fórumokon korábban megfogalmazott legfontosabb kritikákra, félelmekre sem. A Magyar Orvosi Kamara előre jelezte, hogy nem támogatja az erőltetett ütemű, s a hatástanulmányokat is mellőző központosítást. Megíté -
lésük szerint a parlament elé szánt tervezet veszélyezteti szakemberek megtartását a közellátásban, öszszességében pedig az ágazatban „a meglévő bizonytalanságot fokozza”. Azt külön is sérelmezték, hogy az indítvány a miniszterelnökkel korábban kötött bérmegállapodást is felrúgná az alapbércsökkentés lehetőségének bevezetésével. Miután a parlamenten simán átment a kormány tervezete, a kamara vezetői a tagságtól kértek állásfoglalást a továbbiakról. A válaszolók túlnyomó többsége szükségesnek tartotta egy rendkívüli Országos Küldöttgyűlés összehívását, amely a tiltakozás erősebb formáiról is dönthet az új esztendő elején. A hangulatot azonban már most jelzi, hogy a 8300 válaszolóból 4500 közölte, hogy hajlandó letétbe helyezni a felmondását, 6800-an pedig az önkéntes túlmunkaszerződéseiket készek ugyanígy megszüntetni. Beszédesek az arányok is. Az ügyeleti ellátásban ténylegesen résztvevők közül a szakellátóknál 80%, az alapellátásban, illetve a kórházakban dolgozóknál pedig 85% volt azok aránya, akik készek felhagyni a túlmunkával. A felmondások letétbe helyezésére az alapellátásban legnagyobb a
készség (61%), a kórházakban 51%, a szakellátóknál pedig 47%.
Külön is készített egy felmérést a kamara szakorvosjelölti csoportja. Ugyanis megítélésük szerint az átvezénylések, a bércsökkentés, valamint a közreműködői szerződések felszámolása különösen is hátrányosan érinthetik a legfiatalabbakat. A válaszadók 95 százaléka vélte úgy, hogy a tervezett változások a külföldi munkavállalás felé terelhetik a fiatal orvosokat. Az idősebbeket pedig a magánellátás, s – különösen az átszervezni kívánt körzetekből – a nyugdíj felé mozdíthatja a bizonytalanság. Kincses Gyula kamarai elnök az Indexnek úgy fogalmazott: „Az új rendszerrel szemben a félelmünk az, hogy a hagyományos orvosi szemlélettel szembemegy, egy szabályozott, iparszerű, beosztott rendszer felé tolódik az egészségügy, ami kevésbé orvosi szemléletű”. S hogy ennek nem csak az orvosok, hanem a páciensek is közvetlen kárvallottjai lehetnek, arra Svéd Tamás, a kamara titkára említett példát az ATV Híradójának: „Ha a megyén belül bármikor bárhova, akár másfél óra utazásnyira átvezényelhetik hosz” 3. oldal
Kép: hedgehog94/Shutterstock
hirdetés
Budapest, 2022. decemBer www dental-triBune com XV iii éV folyam, 4. szám
The World‘s Dental Newspaper




KIZÁRÓLAGOS MAGYARORSZÁGI FORGALMAZÓ www.alphaimplant.hu Platform switching Kónuszos felépítmény kapcsolat Erősebb és egyenletesebb csatlakozás Kisebb mikromozgás
szabb időre, akkor a megszokott orvosát kereső betege sem fogja őt megtalálni.” Mások azt is kétségbe vonják, hogy szerencsés ötlet a megyék ellátásának átszervezését az amúgy is sok gonddal küzdő megyei kórházak vezetőire bízni, hiszen ők szükségszerűen a saját intézményük működtetéséért küzdenek. Így pedig ez azzal járhat, hogy az alap- és szakellátás szerepe csökken, a gyógyítás távolabb kerül a betegektől, az ellátás pedig összességében drágább lesz.
Az Index nek nyilatkozó Sinkó Eszter egészségügyi közgazdász is az ellátórendszer kórházcentrikusságának további erősödésében látta az egyik legnagyobb fenyegetést. Emlékeztetett: már ma is több megyei kórházban szünetelnek egyes ellátások, s reális veszély, hogy a szakemberhiányukat az irányításuk alá rendelt városi kórházak és szakrendelők dolgozóival próbálják majd pótolni. Így egyre több olyan vizsgálat és kezelés lehet, ami csak a megyei intézményekben érhető el, ahol viszont ezek erősen túlterheltek lesznek. Erre is alapozza Sinkó Eszter azt a jóslatát,
hogy a betegek hozzáférése nem csupán az alapellátáshoz, hanem a szakellátáshoz is romlani fog. S e veszély miatt különösen is hiányolja, hogy az intézkedéscsomag nem is foglalkozik azzal, hogy a betegeknek ellátási garanciákat határozzon meg. Például a tekintetben, hogy egy-egy meghatározott probléma kivizsgálását és ellátását mennyi időn belül garantálja a közellátás?
Ez az intézkedéscsomag egy kulcshiányosságának látszik. Ennek pótlása ugyanis rögtön rávilágítana arra a tarthatatlan helyzetre, hogy a közellátásban mind nagyobb számban vannak olyan fehér foltok, ahol „nincs senki, aki a tb-biztosított beteget fogadná”. Ha pedig többé nem lehetne elfedni e problémát a betegek korlátlan sorbaállításával, akkor az megkerülhetetlenné tenné a közellátás és a magánegészségügy viszonyának régóta halogatott rendezését is. Ez utóbbit a Takács-csomag meg sem kísérelte.
„Mindig leírtuk, hogy a köz és a magán viszonyának rendezése nélkül nem lehet tisztességes egészségügyet csinálni” – emlékeztetett e hiányosság súlyára a már idézett interjúban Kincses Gyula kamarai
elnök. Ő ott ehhez hasonlóan hiányolta azt is, hogy a finanszírozási kérdések sem kerültek napirendre a parlament elé terjesztett törvényjavaslattal együtt.
Miközben sokan várták, hogy a Takács-csomag milyen új megoldásokat próbál ki a régi ágazati problémák megoldására, kibontakozott néhány újabb válság is. A pandémiára jött a szomszédos Ukrajna lerohanása, meg a gazdasági krízis és az energiaválság. „Lassan világossá válik: a ‚boldog békeidőknek’ egy ideig biztosan vége” – állapította meg a fogászat helyzetét bemutató cikkében Dul Zoltán novemberben a Magyar Orvosban. Emlékeztetett, hogy egy év alatt másfél-kétszeresükre is nőttek a fogorvosi anyagok beszerzési költségei, melyeket az általános inflációs lendületen túl az euró–forint árfolyam romlása is emel. Ehhez jön még a rezsiköltségek egyelőre ki sem számítható megugrása. A szombathelyi fogorvos szerint még megjósolni is nehéz, hogy ki lesz nehezebb helyzetben a szakmában: a jelentősen szűkülő kereslet ellenére áremelésre kényszerülő magánfogászatok vagy a költségeiket csak részben fedező állami finanszírozásból működő közszolgáltatók?
Az utóbbiak esetében az új bajok –mint Dúl Zoltán is emlékeztet – néhány régebb óta megoldatlanhoz társulnak. Ilyen például az iskolafogorvosok helyzete, vagy az alapellátó praxisok rendszeres rezsitámogatásában még mindig fennálló 110 000 Ft-os lemaradás a fogászatok kárára. A MOK Háziorvosi Csoportja október-november fordulóján pontosabban is igyekezett felmérni, hogy mekkora bajt okozhat a rezsiugrás a háziorvosoknál, illetve az alapellátó fogorvosoknál. A kérdőívükre érkezett több mint 1600 válaszból az tűnt ki, hogy e tekintetben a fogorvosok praxisai a kiszolgáltatottabbak. Ugyanis azok 80 százaléka magántulajdonú rendelőben működik (háziorvosiaknál: 65%) és 56 százalékuk semmilyen rezsitámogatást nem kap az önkormányzattól (a háziorvosoknál: 41%). Az energiaköltségek mostani megugrása viszont erősen fenyegeti őket: a rendelők több mint kétharmada gázt használ, s több mint felükben nincs is alternatív fűtési mód!
A praxisok gazdái a felmérés idején még nem láthatták az új tarifás téli számlákat, így a várakozásaikról nyilatkoztak. A fogorvosok mintegy
a baktériumok stoppolnának a gombákon” – hogyan „sétálnak” az organizmusok a fogakon keresztül?
Anisha Hall Hoppe, Dental Tribune International
A Pennsylvaniai Egyetem kutatócsoportja megállapította, hogy a baktériumok csoportjai a növekedést követő órákon belül képesek voltak saját testhosszuk több mint 200-szorosát „átugrani” a fogfelszíneken, és ezzel megragadó magyarázatot adtak a gyors bakteriális kolonizáció és a fogszuvasodás hátterében álló mechanizmusra.
Az egyetem sajtóközleményében a társszerző, Prof. Hyun (Michel) Koo, az egyetem Innovációs és Precíziós Fogászati Központjának alapító igazgatója elmondta, hogy bár a laboratóriumban a biofilmet alkotó szervezetek nem voltak mozgékonyak, a baktériumok és gombák kombinációja „szuperorganizmust” hozott létre: egy olyan csoportosulást, amelyet sokkal nehezebb volt eltávolítani a fogakról, mint bármelyik alkotóelemet önmagában.
A kutatócsoport eredetileg kisgyermekek súlyos gyermekkori fogszuvasodását tanulmányozta, amikor megdöbbenve tapasztalták, hogy a baktériumok és gombák keveréke valóban kifejlesztette a „járás” és az „ugrás” képességét, miközben korábban egyikük sem volt képes erre.
A szóban forgó organizmusokat, a Streptococcus mutans-t és a Candida albicans gombát azonosították a kisgyermekek súlyos fogszuvasodását okozó biofilm fő alkotóelemeiként.

Dr. Zhi Ren, a laboratóriumban dolgozó posztdoktori munkatárs és a tanulmány egyik társszerzője a mikroszkópia egy olyan formáját használta, amely lehetővé tette a csapat számára, hogy valós időben megfigyelje a szervezetekben bekövetkező változásokat. A baktériumok és gombák képesek voltak váratlanul nagymértékű tapadást és mikrobiális toleranciát kifejleszteni.
A gombák hifákat hajtottak, amelyek lehetővé tették a baktériumok számára, hogy jobban rögzüljenek és megakadályozzák az eltávolítást.
A biztonságos rögzülés ellenére az új összetétel még mindig képes volt előrehaladni, „mintha a baktériumok stoppolnának a gombákon” – mondta Prof. Koo. Ez a képesség azt jelentette, hogy miután az öszszeállítást laboratóriumi modellben emberi fogakon tesztelték, a biofilm a vártnál sokkal gyorsabban terjedt, mivel az organizmusok növekedésük során képesek voltak mozogni.
Az eredmények nemcsak a fogorvosoknak segíthetnek jobban megér-
teni, hogy milyen szintű megelőzésre van szükség a súlyos szuvasodás megelőzéséhez, hanem a klinikusoknak is segíthetnek megérteni a baktériumok elszaporodását az orvostudomány más területein.
A tanulmány, amelynek címe „Interkingdom assemblages in human saliva display group-level surface mobility and disease-promoting emergent functions”, a Proceedings of the National Academy of Sciences 2022. október 11-i számában jelent meg. DT
ötöde gondolta, hogy legfeljebb duplázódik a számlája, de nagyjából ugyanennyien számítottak arra, hogy legalább a nyolcszorosára ugrik a rezsijük.
A MOK ezek alapján a finanszírozási problémákat enyhítő javaslatokat is megfogalmazott az egészségügyért felelős államtitkárság számára. Így egyebek mellett kérték az iparűzési adómentesség teljes kiterjesztését. (Jelenleg a fogorvos-praxisok kevesebb mint ötöde kap ilyet az önkormányzattól.) Kérték továbbá a rezsitámogatás növelését egységesen 640 ezer forintra. Valamint arra is kértek lehetőséget, hogy a praxisok az önkormányzatok döntésétől függetlenül is önállóan szerződhessenek kedvezőbb tarifákkal az energiaszolgáltatókkal.
A kezdeményezés eredményéről Dúl Zoltán is beszámolt az említett cikkében: „a jelzés a kormányzat részéről egyértelmű: jelen gazdasági helyzetben emelésre és kompenzációra nem számíthatunk”. S a jóslata sem sokkal biztatóbb: „Fel kell készülnünk, hogy egy jelentős ideig együtt kell élnünk az emelkedő inflációval, a lassuló gazdasággal és a csökkenő piaci kereslettel.” DT
IMPRESSZUM NEMZETKÖZI SZÉKHELY
FELELŐS KIADÓ ÉS VEZÉRIGAZGATÓ: Torsten OEMUS
TARTALOMÉRT FELELŐS IGAZGATÓ: Claudia Duschek
Dental Tribune International GmbH Holbeinstr. 29, 04229 Leipzig, Germany Tel.: +49 341 4847 4302 Fax: +49 341 4847 4173
Általános információ: info@dental-tribune.com Hirdetésfelvétel: mediasales@dental-tribune.com www.dental-tribune.com
A Dental Tribune International GmbH azon anyaga, amelyet újra nyomtattak vagy lefordítottak és újból kinyomtattak ebben a kiadásban a Dental Tribune International GmbH szerzői jogi védelme alatt áll. Az ilyen anyagokat a Dental Tribune International GmbH engedélyével lehet csak közzétenni. A Dental Tribune a Dental Tribune International GmbH védjegye. Minden jog fenntartva. © 2022 Dental Tribune International GmbH. A Dental Tribune International GmbH előzetes írásbeli engedélye nélkül bármilyen módon, egészben vagy részben történő sokszorosítása kifejezetten tilos.
A Dental Tribune International mindent megtesz annak érdekében, hogy a klinikai információkat és a gyártók termékeiről szóló híreket pontosan adja közre, nem vállal azonban felelősséget a termékekről szóló állítások helytállóságáért vagy a nyomdahibákért. A kiadó nem vállal továbbá felelősséget sem a terméknevekért vagy -leírásokért, sem a hirdetők közleményeiért. A szerzők által kifejtett véleményt a sajátjuknak kell tekinteni, és azok semmi módon nem tükrözik a Dental Tribune International véleményét.

KIADJA: DP HUNGARY KFT. 1012 Budapest, Kuny Domokos u. 9.
FELELŐS KIADÓ: Laczkó Tamás
SZAKFORDÍTÓ: Laczkó Leonard
NYOMDAI ELŐKÉSZÍTÉS: DP Hungary Kft.
NYOMDAI KIVITELEZÉS: Pharma Press Nyomdaipari Kft.
ADATEGYEZTETÉS, INFORMÁCIÓ: Bárdos Veronika, 06-30-472-0030
HIRDETÉSFELVÉTEL: Laczkó Tamás, 06-30-472-0030
3 Dental Tribune Hungary Edition | 2022/04 EGÉSZSÉGPOLITIKA
“ 1. oldalról
ISSN 1786-9889
„Mintha
A Pennsylvaniai Egyetem kutatói felfedezték, hogy a szájüregi baktériumok gombákkal párosulva olyan organizmustípust hozhatnak létre, amely hihetetlen sebességgel mozog a fogakon, elősegítve a fogszuvasodást. (kép: AnaLysiSStudiO/Shutterstock)
Szemfog és kisőrlő formázása kismetsző aplázia részárással történő kezelése során
Dr. Ivana Dubovská, Dr. Barbora Vágnerová, Dr. Wanda Urbanová (Csehország), Dr. Veiszenbacher Éva, Dr. Borbély Zoltán, Dr. Borbély Péter (Dr. Borbély Fogszabályozási Stúdió, Budapest)
Absztrakt
A hiányzó oldalsó kismetszők részárással történő kezelése során a szemfogak és oldalsó fogak meziális mozgatása közben a fogszabályozó orvosnak csiszolással kell a fogak formáját igazítani. Már a kezelés elejétől a szemfog elcsiszolása nem csak az incizális részre kell hogy kiterjedjen, hanem az approximális, palatinális és a vesztibuláris felszín éli negyedére is. Így érhetünk el egy rövidebb klinikai koronát, a vesztibulo-orális méret csökkenését, egy incizális élt, valamint a szemfog megfelelő pozicionálását a kismetsző helyén. A túl széles szemfog megakadályozza a megfelelő interkuszpidáció kialakítását az oldalzónában. A palatinális felszín elcsiszolásával biztosítjuk az interferenciák nélküli metszővezetést, és a megfelelő overjetet a frontfogak enyhe érintkezésével. Ha a szemfogra a későbbiekben esztétikai pótlás készül, a megfelelő approximális elcsiszolás (az esztétikai fogorvossal történő egyeztetés után) biztosítja a zenith kívánatos pozícióját a későbbi felépítéshez. A mezializált kisőrlő palatinális csücskének elcsiszolására csak akkor van szükség, ha ez akadályozza a megfelelő fogérintkezést. Az első kisőrlő mindkét csücske fontos a már a szemfog helyén álló fog esztétikai és funkcionális beállításához.
Jelen beszámoló célja a fellelhető szakmai irodalom áttekintése, továbbá az eljárás klinikai lépéseinek bemutatása.
Kulcsszavak: szemfog-mezializáció, szemfogformázás, szemfogelcsiszolás, első kisőrlőformázás, első kisőrlő elcsiszolás, hiányzó oldalsó kismetsző (aplázia)
Bevezetés
A szemfog oldalsó kismetsző helyére történő bemozgatása során a fog átalakítása javasolt a két fog eltérő morfológiai adottságai miatt (1. a-b ábra) A fog kontúrozása, vagy úgynevezett formázása magába foglalja az approximális felszínek elcsiszolását, valamint a többi fogfelszín igazítását a kívánt fogformának megfelelően [1].
A kismetsző és szemfog klinikai koronái közötti eltérések a következő-
ek: mezio-disztálisan keskenyebb oldalsó metsző, csücsök hiánya, egyenes éli lefutás, és a vesztibuláris felszín domborulata is kevésbé kifejezett [2,3]. A szemfoggal öszszehasonlítva, az oldalsó metsző rendszerint rövidebb és keskenyebb mind mezio-disztálisan, mind vesztibulo-orálisan. Az átformázott szemfog és az oldalsó metsző anatómiai alakja közötti egyezés függ az elülső zóna mint egység formájától is. Kataoke és Nishimura három alapformát határozott meg az elülső fogak tekintetében: négyszögletes, óvóid és háromszög formájú [4]. A frontfogak vesztibuláris felszínét a három kúp egységeként írják le (kúpos fejlődési mamelonok): meziális, disztális és centrális. A szemfogak esetén a három közül a központi a legdominánsabb, de nem ugyanez a helyzet az oldalsó metsző esetében. Háromszög alakú fogkorona esetén a meziális és disztális érvényesül jobban, négyszögletes formánál mindhárom egyenlő arányban domborodik, míg óvóid forma esetén a középső kerül túlsúlyba. Ennek megfelelően a szemfog csücskét el kell csiszolni, és kompozit felépítéssel az elülső anatómiai formához illő oldalsó metsző alakzatot kialakítani a szélső élek megfelelő hangsúlyozásával [5]. Amennyiben az elülső fogak formája háromszögletes, akkor kifejezett meziális és disztális felépítésekre lesz szükség. Négyszögletes forma esetén a szemfog meglévő centrális kúposságát kiegyensúlyozva építik fel a fogat. Az elülső fogak ovoid alakzata esetén a meziális és disztális kúposságot alig vagy egyáltalán nem hangsúlyozzák (amennyiben a szemfog formája csiszolás után megegyezik az oldalsó metszőfog kívánt alakjával). A szemfogaktól eltérően az oldalsó metszők palatinális felszíne konkáv mind mezio-disztális, mind apikokoronális irányban [6].
Figyelembe véve, hogy apláziás oldalsó metszők esetén általánosan megfigyelhető a fogak méretének csökkenése [7,8,9], egyes pácienseknek a szemfoga is kisebb lehet. Ezekben az esetekben nem mindig van szükség a fogak elcsiszolására, a szemfogakat
ilyenkor felépítésekkel formázzuk, amit gyakran a középső metszők és kisőrlők felépítése egészít ki.
Eszköztár
Az eszközöket két fő csoportra oszthatjuk: kézi- és forgóeszközök.
Kézieszközök - csiszoló csíkok A csiszoló csíkok lehetnek tömörek vagy perforáltak, illetve egy- vagy kétoldalúak. Különböző durvaságú gyémántszemcsékkel vannak bevonva (kék – közepes szemcséjű 45 µm, piros – finom szemcséjű 30 µm, sárga – extra finom szemcsézettségű 15 µm). Ezek nem alkalmasak nagyobb mértékű elcsiszoláshoz vagy formázáshoz. Használatuk az approximális élek lekerekítésére és forgóeszközökkel hozzá nem férhető területek csiszolására korlátozott. Az oldalsó fogak formázásához való alkalmazásuk nem eléggé hatékony, időigényes, továbbá a zománcban érdes, mélyen barázdált és egyenetlen széleket hagynak hátra [11,1].
Forgóeszközök
A forgóeszközök közé tartoznak a keményfém-fúrók, gyémántcsiszolók és gyémántkorongok. A keményfém-csiszolók funkcionális hegye finom szemcséjű karbidból készül volfrám-, kobalt- vagy acélalapon [1]. Eltérhetnek az élek számának függvényében (6, 10, 12, 32), illetve a tekercselésnek megfelelően (zöld – durva, kék – közepes, piros – finom, sárga – extra finom).
A gyémántcsiszolókat gyémántszemcsékkel vonják be, és ezeket a szemcseméret alapján lehet felosztani (fekete – extra durva – 151-213 µm, zöld – durva – 107-181 µm, kék –közepes – 64-126 µm, piros – finom 27-76 µm, sárga – nagyon finom –10-36 µm, fehér – extra finom szemcsézettségű 4-14 µm). A passzív hegyű gyémántcsiszolók csökkentik az approximális élek kialakításának kockázatát [12], és megakadályozzák a lágyrészek sérülését. Ezek az elemek nem rugalmasak, ezért a lecsiszolt fogfelszínek széleinek lekerekítése jó manualitást igényel [13].
A gyémántkorongok tömörek vagy perforáltak, és a felületüket gyémántszemcsékkel vonják be (fekete – nagyon durva - 180 µm, zöld – durva – 120 µm, kék – közepes – 100 µm, piros – finom – 30 µm, sárga – extra finom – 8 µm; perforált – 30 µm). Gyémántkorongokat Tuverson [14] és Zachrisson [15,16] alkalmaztak a fogak átalakításához, melyet Sof-Lex korongokkal történő polírozás követ. Előnyük, hogy gyors redukciót biztosítanak, hátrányuk a megfelelő anatómiai forma kialakításához szükséges lekerekített élek elérésének nehézségében rejlik, ez a merev korongok és a lágyrészek sérülésének nagyobb rizikója miatt áll fenn.
Az oszcilláló mozgást végző speciális 60°-os gyémántkorongok, amelyek könyökdarabban rögzülnek, egy 30°-os tengelyben szintén alkalmazhatók. Két típusú szemcsézettségük van: közepes és finom [1]. Előnyük a ritka lágyrész-sérülés, hátrányuk a hosszabb folyamat, továbbá szorosabb kontaktpontok esetén a vibrációk érzékelése a páciens által [12].
Az elcsiszolt felületek polírozásához az alábbiak alkalmazhatóak: keményfém-csiszolók közül piros (8-12), sárga (16-20) és fehér (30) jelzésűek, sárga és fehér gyémántfúrók és Sof-Lex korongok. A SofLex korongok uretánnal bevont papír polírozó korongok 9, 13 és 16 mm átmérővel. A Sof-Lex XT és a korong egyharmada poliészterből készül. Felületüket különböző méretű alumínium-oxid kristályszemcsék borítják (sötét narancssárga – durva – 40-100 µm szemcsék, narancssárga – közepes – 9-40 µm, világos narancssárga – finom 3-9 µm, sárga – extra finom 1-3 µm) [17].
az okklúziós kulcsnak megfelelően, valamint a szükséges felépítésekhez.
2. Interproximális területek hoz-


záférhetősége
Az approximális felszínek elcsiszolása előtt fontos kialakítani a megfelelő kontaktpontokat, ehhez pedig ki kell nivellálni a fogívet, és meg kell oldani a rotációkat [23]. Ugyanakkor fontos a zenith ideális magassága és megfelelő angulációja. Az esztétikus fogorvos a fogkorona anatómiája és a zenith pozíciója alapján határozza meg a meziális és disztális felszínek elcsiszolásának mértékét. Mivel a középső metsző és a szemfog közötti kontaktpont nem ideális, ezért a szemfog tengelyét úgy kell beállítani, hogy az elcsiszolásokat követően a lehető legjobb érintkezést hozzuk létre a két fog között.
3. Lágyrészek védelme Gyémántkorongok használatakor, a lágyrész sérülések megakadályozásához a négykezes technika vagy egyéb védőelem használata javasolt [16]. Kezdetben a papilla védelmére réz szeparáló drót vagy faék használatát javasolták [24]. Azonban ezt mára már elvetették, mivel megnyitják a kontaktpont területét, illetve a kismértékű papillasérülések nem okoznak fájdalmat a pácienseknek [18]. Napjainkban az inaktív heggyel rendelkező gyémántcsiszolók használata javasolt [12].
4. Fogközi elcsiszolás és formázás Kismértékű elcsiszolással javasolt kezdeni, majd fokozatosan folytatni [25]. Az elcsiszolás mértékét egy speciális mérővel (approximális felszíneknél) vagy tolómérővel ajánlott ellenőrizni. Hasonló az eljárás az interdentális felszínek formázása esetén is. Piros gyémántfúrók [24], gyémántbevonatú [14] és oszcilláló mozgást végző korongok [26] javasoltak.
5. Kidolgozás és polírozás
1. Tervezés Már a kezelési tervezés fázisában meg kell határozni a zománc elcsiszolásának pontos mértékét az egyes fogak esetében [18]. Szemfog oldalsó metszővé való átalakítása során az aranymetszés szabályait vesszük alapul [19-22], vagy készíthetünk egy wax-upot. A beavatkozást megelőzően meg kell határozzuk a kívánt korona magasságát, azaz, hogy mennyit kell elcsiszolni a szemfog csücskéből, és milyen kiterjedésű felépítményre lesz szükség az incizális él kialakításához. Az optimális mezio-disztális szélesség kialakításával egyrészt elegendő helyet biztosítunk a kisőrlő megfelelő pozicionálásához a szemfog helyén
A kidolgozás és polírozás eredményeképpen egy megfelelő morfológiájú, textúrájú és a lehető legsimább fogfelszínt alakítunk ki. Az approximális élek lekerekítettek, és a megmunkálást sárga gyémántfúrókkal fejezzük be [15]. Finom gyémántszemcsézettségű vagy oszcilláló mozgást végző korongok, illetve polírozásra alkalmas keményfém-fúrók alkalmazhatóak a polírozáshoz. A végső finomításokhoz minden szerző Sof-Lex korongokat javasol [27, 18, 28-30].
6. Helyi fluoridálás
Egyes szerzők javasolják topikus fluoridkészítmények alkalmazását a csiszolást követően [31,32]. Zachrisson szerint [15, 33] fluoridtartalmú
4 Dental Tribune Hungary Edition | 2022/04 TUDOMÁNY ÉS KUTATÁS
Az elcsiszolás és formázás klinikai kivitelezésének lépései
1a 1b
Szakirodalmi áttekintés
fogkrém és szájöblítő használata esetén nincs szükség további fluoridzselé alkalmazására. Még egy kis mennyiségű folyadékban található fluorid is (0,03-0,08 ppm), amely kontaktusba kerül a zománccal, remineralizációt eredményez, ez elnyomja a demineralizációt. [34].

Formázás –gyakorlati kivitelezés
A tanulmányunkban bemutatott javaslatokat Zachrisson, Rose és Mirabella előadásaira [35, 36,37] és a fellelhető irodalomra [14,38,39,41] alapoztuk. A megfelelő vízhűtés al-
kalmazása rendkívül fontos része az eljárásnak . A szövegben megjelenő eszközök a Rodentica, Komet és 3M termékei.
Szemfogbecsiszolás A szemfog elcsiszolásához piros gyémántfúró javasolt, finom szem-
csézettséggel, 27-76 µm (okkluzálisan lekerekített – Rodentica, speciális hegyű 806314466514031, Komet 8833), gyorsítóval (max 160 000 fordulat/perc) megfelelő hűtés mellett, legalább 50 ml/perc. Ezt követi a felület kidolgozása és polírozása sárga gyémántcsiszolóval, extra finom szemcsézettséggel, 10-36 µm (Rodentica 806314466504031) és narancssárga Sof-Lex korongokkal (finom alumínium-oxid szemcsék 3-40 µm, extra finom, narancssárga-sárga, alumínium-oxid kristályok mérete 1,7 µm) könyökdarabban (25000 fordulat/perc) megfelelő hűtés mellett min. 50 ml/perc (2. a-d ábra)
A szemfog megfelelő inklinációjának eléréséhez az oldalsó metsző helyén a palatinális felszínt is el kell csiszolni. Ennek a felületnek nem szabad interferenciát okoznia a harapásban, és lehetővé kell tennie a megfelelő metszőfog-vezetést [14].
A formázás előtt meg kell vizsgálni a szemfog vesztibulo-orális pozícióját. Lapos vesztibuláris felszínnel rendelkező szemfog esetén szükség lehet egy elsőrendű hajlításra a középső metsző és szemfog között (főleg, ha a szemfogon egy oldalsó metsző bracket van, melyben a beépített in-out érték magasabb) annak érdekében, hogy elérjük a megfelelő vesztibulo-orális pozíciót a fognyak szintjén, és elkerüljük a palatinális elcsiszolást (3. a-b ábra), [39].
Abban az esetben, ha a szemfognak kifejezettebb a központi lóbusa, a palatinális felszínről is el kell csiszolni, nem csak a vesztibuláris felszínről [40, 41]. A vesztibuláris felszín kifejezett elcsiszolása esetén ez már a dentint is érintheti, ami megnehezíti az esztétikai helyreállítást (a sárga dentin átüthet és a ragasztás is nehezebb ehhez a felülethez). Ezért a vesztibulárisan domború szemfogakat javasolt palatinálisabban pozicionálni, ami – együtt a nagyobb mértékű palatinális elcsiszolással – lehetővé teszi a felépítmény kiterjesztését a vesztibuláris felszínen és a központi lóbus álcázását [39].
A zománc elcsiszolásának mértékét az orális és incizális felszínen a harapás határozza meg, ennek vizsgálatához tükröt és artikulációs papírt használunk [36]. Ideálisan, teljes interkuszpidációban a frontális kontakt olyan enyhe, hogy az artikulációs papír kicsúszik, míg propulzióban, metsző fogvezetésnél a jelölésnek a palatinális felszín incizális harmadában kell lennie mind a középső metszőn, mind a szemfogon. A gyémánteszközök legalkalmasabb formája a palatinális elcsiszoláshoz a lándzsa és rögbi alakú (Komet 0640, piros finom lándzsa Rodentica 806314257514020 (max. 300 000 fordulat/perc), rögbi Rodentica 800314278514020 finom piros (2776 µm) gyorsítóban. Ezt követően könyökdarabba fogott Sof-Lex korongokkal szükséges polírozni (4. a-b ábra).
Szemfog mezializációt követően történik az approximális felszínek igazítása. Elérjük a megfelelő me -
zio-disztális szélességet, és a kontaktpont incizális irányba helyeződik át. Ebben a fázisban mindig szükséges egyeztetni az esztétikai pótlást készítő fogorvossal a szükséges szemfogformáról és a későbbi felépítmény pontos helyzetéről. Az esztétikai fogorvosnak kell eldöntenie a meziális és disztális felszínek elcsiszolásának mértékét is. Az ideális mezio-disztális fogméretet arányok alapján határozzuk meg. Az oldalsó felszínek elcsiszolására alkalmazott eszközöknek egyeneseknek kell lenniük (az elején), melyek alkalmasak a szemfog domborulatainak elcsiszolására és az approximális felszínek párhuzamosítására a fog tengelyével [38].
A legalkalmasabbak a keskeny, rövid, tűhegy alakú fúrók (speciális, rövid, piros tűhegyű Rodentica 806314465514016 (Komet 1385), sárga Rodentica 806314465504016), hosszú tűgyémánt (Komet 0574 és finom piros lándzsa alakú gyémánt Rodentica 806314249514009, extra finom sárga lándzsa alakú gyémánt Rodentica 806314249504009) és hegyes lándzsa (Rodentica sárga hegyes lándzsa 806314540504010, piros 806314540514010) max. 450 000 fordulat/perc (5. a-e ábra)
Zachrisson szerint az approximális felszíneket gyémántfúrókkal és háromszög alakú tűkkel (okkluzális kontúrozók) alakítjuk és kerekítjük le (Rodentica 466, Komet 8833), [42, 35], (6. a-b ábra). Így a pontszerű kontakt területek kiszélesednek. Ezt követi a bukkális és palatinális felszínek megfelelő anatómiai formájának kialakítása. A lekerekítetlen élek megnehezítik a megfelelő pótlás elkészítését, valamint megnövelik a szuvasodás és parodontális érintettség veszélyét [33].
A javasolt eszközhasználati sorrend a következő: piros gyémántfúró (finom 27-76 µm), sárga gyémántcsiszoló (extra finom, 10-36 µm) gyorsítóban megfelelő hűtéssel (5–6. ábra). Alkalmazhatunk gyémántkorongokat vagy oszcilláló mozgásokat végző korongokat is. A polírozást Sof-Lex korongokkal vitelezzük ki (finom-narancssárga 3-40 µm, extra finom – narancssárga-sárga, 1-7 µm), [43,33], (7. a-b ábra). Az approximális felszínek elcsiszolása több lépésben történik megfelelő vízhűtés alkalmazásával és helyi fluoridálással.











Kisőrlő becsiszolása Ha a szemfog helyére mezializált kisőrlő intrúziójára nincs is szükség, a palatinális csücsök akkor is akadályozhatja a harapást és a szemfogvezetést [44]. Ezekben az esetekben elcsiszoljuk a palatinális csücsköt (8. a-b ábra) piros gyémántcsiszolóval (finom, 27-76 µm, éli formázóval – Rodentica speciális tűhegy 806314466514031, Komet 8833 vagy GD – lándzsa Rodentica 806314257514020, Komet 0640) gyorsítóban (max 160 000 fordulat/perc) vízhűtés mellett, min. 50 ml/perc [39]. Extra finom sárga gyémántcsiszolóval polírozunk, 10-36 µm szemcsézettséggel (sárga éli csiszoló Rodentica speciális tűhegyű 806314466504031, GD – sárga lándzsa alakú Rodentica

5 TUDOMÁNY ÉS KUTATÁS Dental Tribune Hungary Edition | 2022/04
2a 2c 2d 2b 3.
között. 3a 3b 4.
4a 4b 5. a-e ábra: A szemfog proximális éleinek beállítása rövidebb tűláng gyémántfúróval (Rodentica 465), továbbá hosszú tűkkel gyémánt láng (Rodentica 249) és hegyes láng gyémántfúróval (Rodentica 540). A bracketeket már eltávolították ezekről a fogakról. 5a 5c 5d 5e 5b
a–b ábra: .019x.025” acél mint befejező fogszabályozóív vesztibuláris hajlításokkal a 11-13., a 21-23., valamint a 24-25. és a 14-15. fogak
a-b
ábra: A szemfog palatinális felületének formázása (a, Rodentica 257) és polírozása narancssárga Sof-Lex koronggal (b). A bracketeket már eltávolították ezekről a fogakról.
806314257504020) és narancs SofLex korongokkal (3M finom, narancssárga alumínium-oxid kristály 3-40 µm nagysággal, extra finom, narancssárga-sárga, 1-7 µm alumínium-oxid kristályokkal) könyökdarabban (25 000 fordulat/perc) legalább 50 ml/min. hűtéssel. Az elcsiszolást több lépésben végezzük, és ezt helyi fluoridalkalmazás követheti.





Megbeszélés
A kutatások azt mutatják, hogy a fog nem sérül annak ellenére sem ahhoz, hogy a szemfogat átalakítsuk egy oldalsó metszőfoggá, és jelentős mennyiségű zománcot kell eltávolítani. Tuverson 0,4 mm zománc elcsiszolás mellett nem regisztrált sérülést a szemfogon [14]. Fillion [45,46] 0,6 mm approximális elcsiszolást javasol. Más tanulmányok szerint a kisőrlők és őrlők interproximális redukciójával – torlódás esetén – 6,4 mm [24] - 9,8 mm [47] helyet nyerhetünk, azaz a kisőrlők területén a még biztonságosan elcsiszolható zománc mennyisége 0,5 mm. A kisőrlők csücskén található zománc vastagsága 2-2,5 mm, és fokozatosan csökken a zománc-cement határig [48]. A disztális felszínen a zománc vastagsága kisebb, mint a meziális felszínen, és nincs összefüggés a fog formája és a zománcréteg vastagsága között [49,50], az 50%-os zománc elcsiszolás még biztonságosnak tekinthető, és nem növeli a fogszuvasodás vagy parodontális betegség kialakulásának rizikóját [23]. Legalább 0,5 mm távolságnak kell lenni a gyökerek között az interradikuláris csont számára, és legalább 0,3 mm-t vesz fel az egészséges periodontális rostrendszer [51]. Sheridan szerint [24] a biztonságos elcsiszolás mértéke az oldalsó fogaknál 1 mm (0,5 mm az egyes approximális felszínekről) és 0,75 mm az alsó metszők területén. Mindig figyelembe kell vennünk a fogtípusonként változó zománcvastagságot, a felületek típusát és az etnikai hovatartozást [52,53].
Zachrisson és Mjör [38] 48 eltávolításra kerülő kisőrlőt vizsgáltak. Ezeket a fogakat átalakították, mint a hiányzó fog helyére mezializált szemfogakat. Ezt követően a kisőrlőket értékelték 1 héttel, majd 5 hónappal az elcsiszolás után. Az eredmények szerint amennyiben a
csiszoláskor megfelelő a vízhűtés és a módosított felszínek öntisztulókká válnak, akkor ezt a formázást el lehet végezni anélkül, hogy a páciensnek ez kellemetlenséget okozna, továbbá alig vagy nem történik változás a pulpa és dentin területén. A szerzők ugyanezt igazolták a következő tanulmányukban is, ahol 37 kismetszővé átalakított szemfogat vizsgáltak meg 10-17 évvel a csiszolás után [41]. Nem volt szignifikáns különb -

ség a csiszolt és csiszolatlan fogak között a mozgathatóság, kopogtatási vagy hőreakció szempontjából. Pulpaszűkületet találtak, de ennek más oka is lehetett. Mikroszkóp alatt vizsgálva mindössze két fog esetében figyeltek meg a gyémántcsiszolók által hagyott barázdákat és karcolásokat, a többi fog állapota tökéletes volt. Fontos, hogy a zománc elcsiszolásnál figyeljünk a természetes fogformára, elsimított zománcfelszínre (mely biztosítja az
öntisztulást) és az elégséges vízhűtésre [38].
Radlanski és mtsai. [54] beszámoltak róla, hogy a perforált korongok 30 µm szélességű és mélységű barázdákat hagynak hátra. Az elcsiszolt felületek extra finom Sof-Lex koronggal történő polírozása után is 10-30 µm mély vájatok maradnak. Ezekben a barázdákban felgyűlhet a plakk, még akkor is, ha a páciens fogselymet használ, és ez növelhe-
ti a fogszuvasodás előfordulásának gyakoriságát [55].
Joseph és mtsai. [32] szerint az elcsiszolás egyedüli hátránya a nem megfelelő felületi kidolgozás és polírozás. Amennyiben a zománcfelszín viszonylag sima a csiszolást követően, úgy nincs plakk felhalmozódás, és a zománc remineralizálódhat. Zachrisson bebizonyította, hogy az elcsiszolást követően azokon a területeken, ahol a plakk felgyűlhet, megnövekedik a fogszuvasodás előfordulása, azaz a durva, a rosszul polírozott és a nehezen tisztítható felületeken. A legnagyobb rizikót az egyenetlenül elcsiszolt approximális zománcfelszínek jelentik [56]. Ezt a problémát megoldhatja az inaktivált végű fúrók használata [12]. Zachrisson 2,5%-os caries előfordulást jelentett az elcsiszolt felszíneken szemben a 2,4%-os gyakorisággal kezeletlen felületeken [56]. Kanoupakis és mtsai. [57] Diagnodenttel dolgozva kezdetleges zománc elváltozásokat az elcsiszolt fogak 4,7%-ánál figyeltek meg 18-24 hónappal a beavatkozást követően. Jarjoura és mtsai. [58] három új interproximá -
6 Dental Tribune Hungary Edition | 2022/04
TUDOMÁNY ÉS KUTATÁS
7. a-b ábra: Polírozás narancssárga Sof-Lex koronggal. 8. a-b. ábra: A páciens a felső első kisőrlő palatinális csücskének elcsiszolása előtt (a) és (b) után, a szemfogvezetés kialakításához. A szemfog vesztibuláris felszínének befejezése. 6a 7a 8a 6b 7b 8b Bracket típus Indikáció Roth torque Roth anguláció MBT torque MBT anguláció Standard edgewise torque/anguláció Oldalsó metsző VO keskeny, elcsiszolás után alkalmas +8° +9° +10° +8° Szemfog VO széles, ha pozitív a torque érték -2° +10° -7° +8° Felcserélt szemfog VO széles, ha pozitív korona torque szükséges +2° +10° +7° +8° Szemfog 0° torque értékkel VO széles, ha nem kell torque 0° +8° 0°/0° Felcserélt alsó második kisőrlő bracket VO széles, ha kifejezett pozitív torque-ra van szükség +22° 0° +17° +2° 1. táblázat: Kismetsző helyére mezializált szemfog bracket kiválasztása. VO – vesztibulo-orális dimenzió.
6. a–b ábra: A proximális szemfogélek lekerekítése, okkluzális kontúr kialakítása (Rodentica 466).
lis lézió megjelenését jelentették 376 fogfelszínt vizsgálva, 1-6 évvel a csiszolást követően. Nem találtak különbséget a caries incidenciában csiszolt és csiszolatlan fogfelszínek között [59,60,61,15,58,41,56]. In vitro az elcsiszolt zománc nagymértékű demineralizációt mutat [62,31], azonban in vivo ezt kiegyensúlyozza a természetes remineralizáció [61]. Azt is bebizonyították, hogy a zománc ásványi anyag tartalma nem változik [28]. Ezért feltételezhetjük, hogy a megfelelőn kialakított és kellően polírozott palatinális és vesztibuláris zománcfelszínek nem jelentenek kockázatot sem a szemfog, sem pedig a kisőrlő esetében.







Különböző szerzők más és más eszközhasználati sorrendet javasoltak a legsimább zománcfelszín eléréséhez . Hein és mtsai. [63] finom szemcsézettségű gyémántkorongokkal indítanak, így a kezdeti barázdák nem lesznek olyan mélyek, és könnyebb a felületet polírozni. 60 másodpercig tartó Sof-Lex korongos polírozás simább zománcfelszínt alakíthat ki, mint a kiindulási felület. Zhong és mtsai. [18] az oszcilláló mozgást végző perforált korongokat részesítik előnyben kisebb mint 30 µmes szemcsenagysággal, a polírozást finom és extra finom Sof-Lex korongokkal végzik 40 másodpercig, megfelelő vízhűtés mellett. Szostkova szerint a perforált
gyémántkorongokkal vagy abrazív csiszoló csíkokkal végzett zománc elcsiszolás polírozás nélkül helytelen [1,73]. Abban az esetben, ha piros és sárga gyémántkorongokat alkalmaztak polírozás nélkül, akkor a sárga csiszoló lekerekítette a piros által hátrahagyott barázdák éleit. Ez az eljárás nem változtatott a vájatok számán vagy mélységén [1,73]. Szostkova eredményei alapján csak azok a zománcfelszínek voltak megfelelően polírozva, ahol Sof-Lex korongokat alkalmaztak. A Sof-Lex korongok használata után a barázdák sekélyek voltak, lekerekített végekkel, egyes helyeken a zománcban nem voltak vájatok, vagy csak olyan jellegűek, amelyek kezeletlen zománcfelszíneken is természetesen előfordulnak [1,73]. Annak érdekében, hogy a lehető legsimább zománcfelszínt érjük el, az elsődleges csiszolás utáni barázdák száma rendkívül fontos. Minél durvább a zománcfelület, annál nehezebb azt tökéletesen kidolgozni és elsimítani [25]. Az érdes zománcfelszín tökéletes elsimítása lehetetlen feladatot jelenthet [28,29,30,54,64,65,66]. Minél finomabb az alkalmazott korong és kisebb szemcsézettségű a gyémántcsiszoló a megmunkálás elején, annál könnyebb, gyorsabb és jobb a zománc polírozása [15,18,27,63].
Azok az eljárások, amelyek keményfém-csiszolókat [27,67], gyémántfúrókat és korongokat [63,67], illetve
oszcilláló mozgást végző korongokat [18] alkalmaznak, melyet Sof-Lex korongos polírozás követ, simább zománcfelszíneket tudnak kialakítani, mint a természetes zománcfelület [18,29,30,64,68,69]. A nagyobb átmérőjű Sof-Lex korongok, approximális felszínenként új korongok alkalmazása és a hosszabb polírozási idő ideális eredményt biztosít [18].
A polírozás fontosságát több tanulmány is kimutatta [28,29,30,54], ahol a polírozás minden esetben csökkentette a felület durvaságát.
A lehető legsimább zománcfelszín kialakításán kívül egy másik fontos célja az elcsiszolásnak a teljes beavatkozás hatékonysága [1], azaz, hogy elérjük a legsimább felületet a lehető legrövidebb idő alatt, és minél kevesebb eszköz használatával. Ezt nagyban befolyásolja az eszközök elhasználódottsága és a választott technika, így a nyomás mértéke, az abrazív szemcsék keménysége és mérete, a csiszolás időtartama, valamint foghoz kötött tényezők, mint a zománc keménysége [70]. A vékonyabb és rugalmasabb eszközök fokozottabb abráziós elhasználódást mutatnak, mint a durvább csiszoló felületek [71]. Minél szélesebb és keményebb a csiszoló eszköz, annál jobb az erő eloszlása a zománcfelszínen [72]. Az eszközök helytelen alkalmazása, mint például túl nagy nyomás használata és szűk kontaktokba való bepréselése, az eszközök de -

formációját és abráziós hatékonyság csökkentését eredményezi [70]. Ezért az eszközöket gyakran kell ellenőrizni és cserélni.
Marek szerint [11] a zománc elcsiszolás ideális szekvenciája: három gyémántkorong alkalmazása durva - közepes - extra finom. Az extra finom korongokkal való megmunkálás után voltak a legkisebbek a barázdák, mert ezek mérete megegyezik az eszköz szemcseméretével. Ez a folyamat azonban időigényes, és így alkalmatlan a klinikai gyakorlatban. 30 µm-es szemcsenagyságú perforált korongok használata, melyet az extra finom gyémántkorong és két Sof-Lex korongos polírozás követ, a természetesnél is simább zománcfelszínt eredményeznek. A szerzők szerint ez a leghatékonyabb eljárás. Szostkova [73] ugyanerre a következtetésre jutott, számára a leghatékonyabb elsőnek a piros gyémántcsiszoló használata, melyet két Sof-Lex korongos polírozás követ. A szemfog oldalsó metszővé való átalakításában a gyémántkorongok alkalmazása nem elég hatékony, mivel a felületeket az oldalsó metsző formájának megfelelően kell kialakítani, és erre a gyémántcsiszoló sorozat javasolt [28,38,67,74]. Ezek formája segít létrehozni az ideális lekerekítettséget és a sima átmeneteket. A legjobb sorrend: piros gyémántcsiszolóval levenni a szükséges zománcmennyiséget, sárgával lekerekíteni, majd megmunkálni
és polírozni Sof-Lex korongokkal [18,27,28,29,30].


Következtetés
A kismetsző helyére mezializált szemfog elcsiszolása, ha helyesen végezzük el, egy rövidebb szemfogat eredményez, incizális él kialakításával, a vesztibulo-orális és mezio-disztális méretek csökkentésével az oldalsó metszőfog alakjának megfelelően. Így biztosított a metszőfog-vezetés interferenciák nélkül, megfelelő horizontális lépcső enyhe frontfog érintkezéssel, továbbá a kívánt zenith pozíció a későbbi felépítéshez. A kisőrlő palatinális csücskének elcsiszolására csak akkor van szükség, ha a csücsök gátolja a dinamikus okklúziót. Ily módon biztosított a szemfogvezetés. A helyes formázás lehetővé teszi a fogazat funkcionális és esztétikai helyreállítását. A csiszoló eszközök javasolt sorrendjének betartása, melyet a megfelelő vízhűtés mellett végzett polírozás egészít ki, a figyelemmel követett fog- és zománcmorfológia olyan sima zománcfelszínt eredményezhet, mely képes az öntisztulásra, és így nem növeli a caries veszélyét, valamint nem károsítja a fogat.


(A cikk során felhasznált irodalom jegyzéke a szerkesztőségünkben megtalálható.)

7 Dental Tribune Hungary Edition | 2022/04 TUDOMÁNY ÉS KUTATÁS
9024 Győr, Csokonai u. 10. labor@dentartttechnik.hu www.dentarttechnik.hu +36 30 682 3827 Virtuális terezés Ti és CoCr 3D nyomtatása Egyéni implantátumok Egyedi titán zsalúhálók Csontpótlás Csontpótlás eszközei Implantólógiai fúrósablonok Műtéti segédeszközök Impl lantológiában és csontpótlásban az első!
hirdetés
Aggasztó fogászati statisztikák Angliában
Iveta Ramonaite,
Dental Tribune International







hirdetés
Augusztus végén a Nemzeti Egészségügyi Szolgálat (NHS) közzétette az éves fogászati statisztikákat Angliára vonatkozóan. A jelentés a 2022 márciusáig tartó 12 hónapos időszakra vonatkozóan nyújt tájékoztatást az NHS fogászati tevékenységéről az országban, és tartalmazza az NHS fogorvosok által 2022 júniusának végéig ellátott betegek számáról szóló adatokat.

A SARS-CoV-2 terjedésének korlátozása érdekében az angliai fogorvosi rendelőket arra utasították, hogy 2020. március 25-től zárjanak be, és csak sürgősségi ellátást nyújtsanak, amíg a kormány be nem jelentette, hogy 2020. június 8-tól újra megnyithatnak. A jelentés szerint a 2022. március 31ét megelőző 24 hónapban mindössze 16,4 millió felnőtt (34%) vette igénybe az NHS fogászati ellátást. Hasonlóképpen 5,6 millióra (44,8%) csökkent az NHS fogorvos által felkeresett gyermekek száma. A Brit Fogászati Szövetség (BDA) szerint a világjárványt megelőző utolsó teljes évben 48,6%, illetve 58,7% volt ez az arány. Emellett az adatokból kiderült, hogy 2021 és 2022 között mindössze 26,4 millió NHS-rendelésre került sor, míg a világjárványt megelőző öt évben átlagosan 39,4 millió fogászati kezelésre került sor évente. Sajnálatos módon, bár a fogorvosoknak idén áprilistól a pandémia előtti tevékenységük 100%-át kellett elvégezniük, a BDA megjegyezte, hogy a kiszabott célok nem eredményezték az NHS fogászati ellátások mennyiségének növekedését.


Az NHS súlyosbodóegyreválsága és fenyegető halála
A karantén időszak kezdete óta az NHS óriási beteghátralékkal küzd a fogorvosi szolgáltatások korlátozott hozzáférhetősége miatt. Az NHS fogorvosi válság valódi mértékére rávilágítva a BBC által nemrégiben végzett kutatás arról számolt be, hogy tízből kilenc NHS-rendelő közölte, hogy nem tud új felnőtt pácienseket fogadni.
A BDA a közelmúltban Angliára vonatkozó fogászati statisztikákra reagálva megjegyezte, hogy az ország fogászati szolgáltatásainak reformja érdekében sürgős radikális változtatásra van szükség.
„Az NHS fogászat fényévekre van attól, ahol lennie kellene. Hacsak a miniszterek nem lépnek fel, és nem hajtják végre a nagyon szükséges reformot és a megfelelő finanszírozást, ez marad az új normális állapot” – mondta sajtóközleményében

9 Dental Tribune Hungary Edition | 2022/04 SZÍNES HÍREK A NAGYVILÁGBÓL
Online magazinok Előfizetés megrendelése: www.dental.hu 16 újság + 16 e-Journal 45%41 000 Ft helyett 23 500 Ft
Dr. Eddie Crouch, a BDA főigazgatói bizottságának elnöke. DT
Az NHS England által nemrégiben közzétett jelentés szerint az elmúlt években megdöbbentő mértékben csökkent az NHS fogászati szolgáltatásait igénybe vevő betegek száma. (Kép: LunaKate/Shutterstock)




Upgrade Congress új helyszínen, a Hungexpo „Cˮ kongresszusi központjában












VIII. UPGRADE CONGRESS Fogászati Kiállítás és Kongresszus 2023. március 24–25. Mit hoz a 2023-as esztendő a fogászatban? Milyen új trendek, eljárások, technológiák várják a mindig megújuló szakmát? Hogyan tud versenyképes maradni a nyitott és egyre zajosabb nemzetközi piacon? A
rendezvényre Önt is
nem elégszik meg
körű,
koncepciót
mutat be
VIII. Upgrade Show 2023 VIII. UPGRADE HUNGEXPO implantológia • esztétika • endodontia orthodontia • digitális fogászat • prevenció Early Bird kedvezmény január 31-ig! Jelentkezzen most: www.upgradecongress.hu KÉT NAP A JÖVŐÉRT – Lépjen velünk hipertérbe! Dr. Luigi Canullo Dr. Felkai Tamás Dr. Borbély Judit Dr. Baktai Zoltán Dr. Farkas Péter Dr. Fráter Márk Dr. Gurzó Mária Dr. Jakab András Dr. Zsoldos Márton Dr. Döbrentey Zsolt Dr. Antal Márk Dr. Nagy Zsolt
továbbképző
várjuk, ha
a tegnapi ismereteivel, és mind elméleti, mind gyakorlati megközelítésben lépést akar tartani a világgal. A szervezők korábbi tapasztalatai és a nemzetközi rendezvényeken gyűjtött új ismeretek alapján egy szélesebb
átfogóbb
és tematikát
a
Az eddigi első tanulmány kapcsolatot talált az e-cigaretta és a fogszuvasodás előfordulása között
Iveta Ramonaite, Dental Tribune International




A Tufts University School of Dental Medicine kutatói az e-cigaretta használat és a szájhigiénia romlása közötti kapcsolatra vonatkozó meglévő bizonyítékok kiegészítéseként nemrégiben értékelték az e-cigaretta és a párologtató eszközök használata és a fogszuvasodás kockázati szintje közötti összefüggést. Megállapították, hogy a párologtatás növelte a betegeknél a fogszuvasodás kialakulásának kockázatát. Az eredmények alapján azt javasolták, hogy az e-cigaretta és a vaping eszközök használatát ne csak a rutinszerű fogászati és kórtörténeti kérdőívekbe foglalják bele, hanem tekintsék a páciensek fogszuvasodás kockázati szintjét növelő kockázati tényezők közé tartozónak is.

A Betegségellenőrzési és Megelőzési Központok (CDC) szerint körülbelül 9,1 millió amerikai felnőtt és kétmillió tinédzser használ dohányalapú párologtató termékeket. Annak ellenére azonban, hogy egyre több bizonyíték utal arra, hogy a párologtatás a rendszer egészségének romlásához vezet, a közvéle-
mény kevéssé ismeri ezt a kérdést. Korábbi kutatások arról számoltak be, hogy az elektronikus párologtató eszközök használata növelheti a parodontális betegségek kialakulásának kockázatát és károsíthatja a fogzománcot. Azonban több kutatásra volt szükség ahhoz, hogy megértsük az e-cigaretta használata és a szájüregi egészség közötti kapcsolatot, és ez a tanulmány volt az első, amely a vaping és a fogszuvasodás fokozott kockázata közötti összefüggést vizsgálta.
A tanulmányban a kutatók több mint 13 000 olyan 16 évnél idősebb beteg adatait elemezték, akiket 2019 és 2022 között a Tufts fogászati klinikáin kezeltek. Azt találták, hogy az e-cigarettát pároló vagy használó betegek mintegy 79%-ánál magasabb volt a fogszuvasodás kialakulásának kockázata, míg a kontrollcsoportnál ez az arány csak 60% volt. A kutatók megjegyezték, hogy nem vizsgálták, hogy a használt eszközök nikotint vagy tetrahidrokannabinolt, a kannabiszban található

fő pszichoaktív vegyületet tartalmaznak-e. „Fontos megérteni, hogy ezek előzetes adatok" – mondta a sajtóközleményben a kutatás vezető szerzője, dr. Karina Irusa, az egyetem átfogó gondozásának adjunktusa. „Ez nem 100%-ban bizonyító erejű, de az embereknek tisztában kell lenniük azzal, amit látunk" – tette hozzá. A kutatók szerint az e-cigaretta használata hozzájárulhat a fogszuvasodás kialakulásához a magas cukortartalom és a párologtató folyadék viszkozitása miatt. Aeroszolos formában és belélegezve a folyadék a fogakhoz tapad, és a párologtató aeroszolok megváltoztatják a szájüregi mikrobiomot, lehetővé téve a fogszuvasodásért felelős baktériumok bejutását a szájüregbe. Kimutatták azt is, hogy a vaping olyan területeken is elősegítheti a fogszuvasodás kialakulását, ahol az általában nem fordul elő, például az elülső fogak alsó szélén.
Az eredmények fényében a kutatók azt javasolták, hogy a fogorvosok a
kórtörténet felvétele során kérdezzék meg a pácienseket az e-cigaretta használatáról. Ez a gyermekfogorvosokra is vonatkozik, mivel az Egyesült Államokban magas az e-cigarettát használó közép- és középiskolás diákok száma, amely 2021-ben elérte a 7,6%-ot - közölte a CDC.
Emellett a kutatók úgy vélik, hogy az e-cigarettát használó betegeknek szigorúbb fogszuvasodás-kezelési protokollt kellene követniük, amely magában foglalhat vényköteles erősségű fluoridos fogkrémet és fluoridos öblítést, munkahelyi fluoridos alkalmazásokat és nagyobb számú fogászati ellenőrzést.
„A fogszuvasodás kezelése sok időt és pénzt igényel, attól függően, hogy mennyire súlyos a helyzet" –jegyezte meg dr. Irusa. „Ez egy ördögi kör, amely nem fog megállni" – zárta gondolatait.
A tanulmány, melynek címe: „A comparison of the caries risk between patients who use vapes or electronic cigarettes and those who do not: A cross-sectional study”, a Journal of the American Dental Association 2022. decemberi számában jelent meg. DT





















Curen® szálak: gyengéd és hatékony Csepp formájú 22.000 - 42.000 mozdulat/perc

7 tisztítási fokozat
Nagy teljesítményű motor
12 Dental Tribune Hungary Edition | 2022/04 SZÍNES HÍREK A NAGYVILÁGBÓL
SZÓNIKUS FOGKEFE Innovatív svájci kefefej technológiával
www.sagerdental.hu
CURACURVE® tökéletes dőlésszög a nehezen elérhető területek tisztítására power 0 10 10 15 0 sensitive egycsomós 0 hirdetés
Egy új kutatás arról számolt be, hogy az e-cigaretta és a vaping eszközök használata összefügg a fogszuvasodás magasabb kockázatával. (Kép: art_of_galaxy/Shutterstock)
Az éppen aktuális lízing és pályázati lehetőségekről naprakész információval állunk rendelkezésre. Az ügyintézést vállaljuk és nagy raktárkészletünkről gyorsan szállítunk.
CS 9600

3D CBCT szkenner
Páratlanul vékony – 75 µm - 150 µm* – szeletvastagságok, kisebb sugárterheléssel
FOV térfogatok: 4x4/5x5/6x6 cm, 5x8 cm, 8x5/10x5/12x5 cm, 8x8/10x10 cm, 12x10 cm, 16x6 cm, 16x10 cm, 16x12 cm, 16x17 cm






• 5 az 1-ben:


• Fogászati, arc-, és szájsebészeti, orthodontiai, fül-orr-gégészeti vizsgálatokhoz






• Ultra éles panoráma felvételek
• CS MAR – mesterséges intelligenciával támogatott fém műtermék szűrés
• 4 az 1-ben:





















• 120 kV a jobb képminőségért, kisebb sugárterheléssel

• CAD/CAM kompatibilis, teljesen nyitott, stl, Pal formátum



• Dicom kompatibilis
3D CBCT szkenner

















• Fogorvosok, szájsebészek, implantológusok részére
• Teljes digitális panoráma program, tűéles képekkel
• FOV térfogatok: 4x4 / 5x5 / 8x5 / 8x9 / 12x5 / 12x10 cm









• A létező legvékonyabb szeletvastagság: 75 µm - 150 µm




• CS MAR
• CAD/CAM kompatibilis

A Carestream 8000-es családja – 8100, 8100SC, 8100SC 3D, a CS 8200 3D valamint a CS 9600 gépek teleröntgen kiegészítéssel szállíthatók.


















A leggyorsabb telefelvételek, rövid exponálási idők segítik a hatékony munkát. Képméretek: 26x24 cm, 18x24 cm, 18x18 cm
Telepprogram: koponya, standard, oldalirányú felvétel, frontális AP és PA, kézfej Autotracing fogszabályozási segédeszközként használható pontfelismerő rendszer Két szenzor jobb, mint egy! Második beépített szenzorral készülnek a telefelvételek.
CS 2200
Intraorális falikar, szuperszép képminőséggel a 300 kHz-nak köszönhetően
Automatikus expozíciós timer
Vezetéknélküli kivitel Ultrakönnyű Még precízebb, még gyorsabb. Megnövelt mélységélesség
Intraorális falikar, szuperszép

Dent-East Kft. 1112 Budapest, Rétkerülő út 51. • Telefon (06) 1 319 45 68 • e-mail:
mail@dent-east.com • www.dent-east.com
CS 3700 orálszkenner CS 3800 orálszkenner CS 2100 RVG 6200 S-1 RVG 5200 S-1 www.dent-east.com
képminőséggel a 300 kHz-nak köszönhetően Félautomata expozíciós timer. Direkt digitalizáló szenzor. Valós felbontása: 24 vp/mm Direkt digitalizáló szenzor. Valós felbontása: 16 vp/mm Azonnali képmegjelenítés. Minden intraorális röntgengéppel kompatibilis. CS ScanFlow Prémium kevés lépésből álló gyors munkafolyamatú szoftver. Teljesen nyitott rendszer: .stl, Pal, minden applikációhoz Gyors szkennelési idő Kisméretű fej Nagyfokú precizitás Full HD képek
Új
CS 8200 Neo
Orális rehabilitáció egyrészes, Alveo Line cirkóniumimplantátumokkal
Prof. dr. Andrea Borgonovo
Az egyrészes kerámiaimplantátumok, a morfológiájuk miatt, pontos klinikai indikációkkal rendelkeznek a sikeres esztétikai és funkcionális rehabilitációhoz. Különösen a specifikus esetekben, a cirkóniumimplantátumok megfelelő, stabil működésű, kielégítő ellátási lehetőséget jelentenek.
Egy 65 éves férfi páciens esetét mutatta be a Milánói Egyetemen, a Stomatologico Italiano Intézet fogászati részlegének vezetője, Dino Re professzor. Új pótlásra volt szüksége több hiányzó és néhány teljes mértékben roncsolt fog helyére a bal alsó állcsontban. A 35-37-es gyökérmaradványokat már nem lehetett megmenteni (1, 2. ábra). A beteg orális állapotának figyelembe vételével úgy döntöttek, hogy a gyökérmaradványokat eltávolítják, majd azt követően két egyrészes cirkóniumimplantátumot (whiteSKY Alevo Line, bredent) ültetnek be a 35-ös és a 37-es fogak helyére. Az új design-nal rendelkező Alveo Line implantátumok olyan vállrésszel rendelkeznek, amely szükség esetén lehetővé teszi a csontrepedésekkel járó vagy például a Socket Shield technikával előkészített augmentálást. Így a felszívódás az implantátum és a postextraktív csont között megelőzhető. Ebből adódóan, a moláris régióban felhasznált implantátumtest, a stabilitása és az egyéni alkalmazkodóképessége miatt, lehetővé tesz egy jobb emergenciaprofilt és az egyrészes rendszereknél, a hiányzó csatlakozás miatt, egy jobb csonttámogatást biztosít.
Tervezés
A megmaradt csonttérfogat értékeléséhez és a beavatkozás szimulálásához DVT felvételt (3D-Rendering-Software) készítettek (3–5. ábra). Figyelembe kell venni, hogy az implantátum behelyezéshez egy radiológiailag ellenőrzött, minimum 8 mm-es csontmagasság szükséges a csontos képleteknél, úgymint állcsonti öböl, orrüreg vagy canalis mandibulae. A mesio-disztális térségben a proximális felületek között minimum 1,5–2 mm távolságot kell tartani az implantátum és a szomszédos fogak között, hogy elkerülhető legyen az interproximális csontfelszívódás és a papillák elvesztése az ebből eredő esztétikus problémákkal együtt. (6). A háromdimenziós rekonstrukció elemzéséhez a sebész két egyrészes kerámiaimplantátum behelyezését tervezte a 35 és 37 régióban (4 x 10 mm, whiteSKY


Alevo Line, bredent) (7). A morfológiából adódóan az egyrészes implantátumok tervezésekor, az esztétika és funkcionalitás figyelembe vételével, a sebészeti és protetikai protokoll betartása nagy jelentőséggel bír.

Ennek okán a kezelési terv elemzésekor felmerült az irányított sebészeti beavatkozás alkalmazása. A tökéletes cél eléréséhez a beavatkozást egy sebészeti sablon tervezésével valósították meg (7. ábra). Egy héttel a műtét előtt professzionális fogtisztítást végeztek a betegen. A műtéthez szükséges hozzájárulási nyilatkozatot az alternatív implantátumokról, kezelési és ellátási lehetőségekről szóló részletes tájékoztatás után írta alá a páciens. A páciens számára szükséges gyógyszereket összeállították és előkészítették.
Sebészet
A sebészeti fúrósablon behelyezése után megtörtént a beültetési helyek előkészítése a sebészi kézidarabba behelyezett előfúróval, bőséges vízöblítés mellett, a pozició megjelölésével. Ezután a pilótafúróval, majd a kalibrált fúrószárakkal, meghatározott ütközők használatával, előkészítették a furatokat a tervezett implantátumhosszakra. A furatok előkészítésének befejezése után a két kerámiaimplantátumot , hűtés nélkül, szabályozott nyomatékú mechanikus behajtó eszközzel, alacsony sebességgel helyezték be (9–11. ábra). A cél az volt, hogy a csontstruktúra ne legyen túlterhelve, és hogy az azonnali terhelés esetén a csontot vitálisan megtartsák. A kerámiaimplantátumok helyzetének ellenőrzéséhez intraorális röntgenfelvételt végeztek közvetlenül a beültetés után (12).
Ideiglenes ellátás
Közvetlenül a műtét után a pácienst egy protetikai sapkára rögzített ideiglenes pótlással bocsájtották el. Előzőleg az implantátumok protetikai sapkáit akrilgyanta felhasználásával ragasztották be az ideiglenes pótlásba (13., 14. ábra). A csonkon lévő vízszintes barázda megkönnyíti az ideiglenes, és aztán a végleges restauráció rögzítését, pozicionálását (15. ábra)
Összegzés
A whiteSKY Alevo Line (bredent) egyrészes cirkóniumimplantátumok különösen olyan állcsontrégiók azonnali ellátására alkalmasak, amelyekben fogak extrakciója történt. Különösen fontos megemlíteni a moláris és a premoláris
területeket. Az egyrészes implantátumtest nagy stabilitással rendelkezik. A szövetstruktúrák és a klinikai ellátás optimális fenntartása érdekében a sebész választhat a lágyszövetek közötti hely, illetve az extrakciós alveolusok Socket Shield technikával vagy PET-tel történő feltöltése között. A whiteSKY Alveo Line hozzájárul az emergenciaprofil javításához. Az implantátum széles válla az azonnali implantáció során feltölti az extrakciós alveolust. A szövetbarát felület optimális feltételeket biztosít a lágy szövetek rétegződéséhez. Ezenkívül az implantátumrendszer lehetővé teszi a kezelő számára, hogy az implantátumot a klinikai eset követelményeinek megfelelően állítsa be és individualizálja.
További szerzők: Bosotti Lodovico, Censi Rachele, Dino Re, Galbiati Simone
IRÁNYVONALAK, ALKALMAZÁSOK
teszi az
individualizálását
eset követelményeinek megfelelően. ― 7. ábra: Fúrósablon irányított műtétekhez. ― 8. ábra: Fúrási folyamatok
szükséges behelyezési mélység és szélesség eléréséhez. ― 9. ábra: Az implantátum pozícióinak ellenőrzése fúrósablonnal. ― 10. ábra: Az implantátum minimálisan invazív behelyezése utáni állapot. ― 11. ábra: Post insertionem röntgenes ellenőrzés. 1. ábra: Klinikai alaphelyzet. ― 2. ábra: Röntgenkontroll: A gyökérmaradványok 35–37 nem tarthatók meg. ― 3. ábra: A DVT-ben háromdimenziós elemzés készül digitális tervezőszoftverrel, és a következők figyelembevételével: ― 4. ábra: ...a nervus alveolaris inferior a 35 és 37 implantátumok optimális implantátumpozícióit tervezi. ― 5. ábra: A keresztszelvényben az egyes implantátumok szögállása és hossza mérhető vagy elemezhető. 12. ábra: Az implantátumok zárókupakjait ... ― 13. ábra: ... ideiglenes ellátáshoz helyezték fel. ― 14. ábra: Végleges ellátás: A kerámia burkolatú cirkónium-oxid hídváz. ― 15. ábra: Az okklúziós érintkezők ellenőrzése a végleges pótlás behelyezése után. 14 Dental Tribune Hungary Edition | 2022/04
6. ábra: A whiteSKY Alveo Line lehetővé
implantátum
a klinikai
a
ÉV KUTATÁS
CARIES, ABRÁZIÓ ÉS ERÓZIÓ kezelésében és

megelőzésében
Gyorsan remineralizálja az erősen demineralizálódott zománcot és dentint. Növeli az ellenállást a saverózióval, abrázióval és a bakteriális behatásokkal szemben.
Magas cariesrizikójú, előrehaladott kopással és szájszárazsággal rendelkező betegek számára javallott. Ideális fogszabályozó kezelések alatt és után, illetve fogfehérítést követően.
Adjuváns kezelés fehér foltok (caries incipiens) és MIH esetén.
NEMZETKÖZI SZABADALOM
Multicentrális tanulmány* kimutatta, hogy a Biosmalto Cavities Abrasion & Erosion fogkrém az egyetlen, amely biomimetikus hatást mutat, amely képes elősegíteni a fogfelszínek remineralizációját, újonnan képződött hidroxiapatit kristályokkal. Bizonyított az S-HAp mikrokristályok képződése, amelyek szabályos, kompakt megjelenésűek, és a meglévő természetes zománcprizmákkal azonos szerkezetűek és elrendezésűek.
CURASEPT BIOSMALTO – TUDOMÁNYOSAN BIZONYÍTOTT


* Biomimetic toothpastes and mousses for enamel remineralisation.





AUTHORS: Ionescu Ac., Izzo D., Pulcini MG., Dian A., Brambilla E. University of Milan (Italy), Oral Microbiology and Biomaterials Laboratory. Galeazzi Orthopedic Institute, IRCCS (Scientific Institute for Research, Hospitalization and Health Care),Dental Clinic. Academic Board, Naples (Italy) 2019. Poster Code MAT05. Journal of Osseointegration 2019

Bővebb információért olvassa el a használati útmutatót és a f igyelmeztetéseket! (2022. 08. 30.)

Orvostechnikai eszköz.
Bővebb információ a termékekről!
ÚJ SZÖVETSÉGES
A
24
3
7
KLINIKAI- ÉS ESETTANULMÁNY
Mousse rendelői és otthoni használatra Szájöblögető Fogkrém
Kezeletlen fog
Hivatalos magyarországi forgalmazó: Sager Dental Kft. Tel: +36-1-324-2440 www.sagerdental.hu
Kezeltfog
Dr. Agnė Mališauskienė (Litvánia)
Az elmúlt évtizedben a rögzített és az aligner fogszabályozás vált a kezelés standardjává. A fogak preparálásával és koronákkal járó nagyszabású mosolyátalakítások helyett a páciensek gyakran választják a konzervatívabb utat – az igazítást és szükség esetén az additív fogszabályozást. A fogszabályozás befejezése után a pácienseknek gyakran van szükségük a kopott metszőélek helyreállítására vagy a diasztémák lezárására. A kompozit rezint általában a költségek [4] és a minimális invazivitás miatt választják. A kompozit kiváló esztétikát és hosszú élettartamot biztosít [1,2].
A pácienst a fogszabályozó orvosa utalta be. Aki nemrégiben fejezte be a fogszabályozó kezelést (1. ábra előtte és 2. ábra utána. Dr. Vaiva Jakstiene jóvoltából).
A fogszabályozó orvos az oldalsó metszőfogakat 1 mm-es réssel helyezte el a mesialis és distalis oldalon a harmonikusabb mosoly elérése érdekében. A RED arányt választottuk referenciának [5] (3., 4. ábra)
A restauráció napján a fogakat kofferdámrendszerrel izolálták (5. ábra), a felső oldalsó fogak measialis és distalis interproximalis felületét homokfúvással, maratással, öblítéssel, szárítással, 8. generációs ragasztó alkalmazásával, léghígítással és fénykeményítéssel látták el. A diasztémák helyreállításához közepes opacitású kompozitgyantát (testszín) használtunk a kifogástalan optikai integritás elérése érdekében [3] (6-10. ábra)

A kompozitot csak interproximálisan adtuk hozzá, a bukkális felület elfalazása nélkül. A kevesebb kompozit koncepció a szerző szándéka szerint olyan koncepció, ahol csak olyan kompozit kiegészítéseket alkalmaznak, amelyek szükségesek a hiányzó fogszerkezet helyreállításához. A nem szükséges felületeket nem fedik műgyantával.
A féléves visszahívás a kompozit rezin tökéletes integrációját mutatja a fogszerkezetbe (11. ábra)
A fogszabályozó kezelés utáni kompozit restaurációk gyakoriak. A klinikus célja, hogy a fogakat észrevehetetlen, élethű restaurációkkal állítsa helyre. A kopott fogak, diasztémák lezárása minimálisan invazív megközelítéssel érhető el a preparálással és a felhasznált kompozit rezin mennyiségével is.
Irodalom

1. Katsarou T, Antoniadou M, Papazoglou E. Effectiveness of optical illusions applied on a single composite resin veneer for the diastema closure of maxillary central incisors. Int J Esthet Dent 2017;12:42-59.









2. Lempel E, Lovász BV, Meszarics R, Jeges S, Tóth Á, Szalma J. Direct resin
composite restorations for fractured maxillary teeth and diastema closure: A 7 years retrospective evaluation of survival and influencing factors. Dent Mater 2017;33:467-476.

2011;23:73-87.

16 Dental Tribune Hungary Edition | 2022/04 GYAKORLÓ FOGORVOS AJÁNLJA
3. Villarroel M, Fahl N, De Sousa AM, De Oliveira OB Jr. Direct esthetic restorations based on translucency and opacity of composite resins. J Esthet Restor Dent
4. Waning A. Direct or indirect restorative dentistry-a mere choice about cost in relation to longevity? Dent Update
5. WARD, D. H. (2007). A Study of Dentists’ Preferred Maxillary Anterior Tooth Width Proportions: Comparing the Recurring Esthetic Dental Proportion to Other Mathematical and Naturally Occurring Proportions. Journal
Esthetic and
Kevesebb kompozit koncepció a diasztémák lezárására 1. 3. 5. 6. 7. 8. 10. 9. 11. 2. 4.
2011;38:5-10.
of
Restorative Dentistry, 19(6), 324–339.
A PERIIMPLANTÁRIS


EGYSZERŰSÉG ÉS HATÉKONYSÁG

Straumann® TLX Implantátum rendszer Az ikonikus Tissue Level és az azonnali terhelés találkozása A Straumann TLX implantátum rendszer kialakításánál számításba vették a keményés lágyszövet gyógyulás kulcsfontosságú elemeit. Az implantátum-felépítmény kapcsolat távolabb került a csonttól, ezzel jelentősen csökkentve a gyulladás, valamint a csontreszorpció esélyét. Keresse helyi Straumann képviselőjét vagy látogasson el a www.starumann.com/tlx oldalra! AZONNALI
PROTOKOLOKRA KIFEJLESZTVE Kúpos forma az optimális primer stabilitásért
TERHELÉS
egyszerűbb
EGÉSZSÉG FENNTARTÁSA Kevesebb megtapadó baktérium és
tisztíthatóság
KIVÁLÓSÁG AZ AZONNALISÁGBAN
Egyfázisú folyamat, amely szöveti szintű restaurátumot és jobb szék melletti időkihasználást tesz lehetővé
Alpesi Fogászati Szerviz és Kereskedelmi
Kft.
9024 Győr, Eörsy Péter út 13. : 06-20-951-8312, 06-20-328-2441
) alpesi@alpesi.hu, web: www.alpesi.hu




Metasys amalgámszeparátorok, kezelőegységek, kézidarabok, száraz- és nedves elszívók, kompresszorok, autoklávok. Szerviz és kereskedelem. Metasys, Kavo, Planmeca, W&H, Prestige Medical, Stern Weber, Dürr, A-Dec, Woodpecker
Dentalcoop Plus Kft. –Kenedli


Flórián
9700 Szombathely, Sárvár utca 12.
/fax: 06-94/318-590, mobil: 06-20/9565-480
) info@dentalcoopplus.hu, www.dentalcoopplus.hu Orvostechnikai eszközök (panoráma- és intraorális röntgen, autokláv, hőlégsterilizátor)

időszakos felülvizsgálata! Kezelőegységek, panoráma- és intraorális röntgenek,autoklávok, kézidarabok, kompresszorok (Stern Weber, MyRay, Cattani, Nouvag, NSK, KaVo, W&H, Anthos, OMS, Planmeca,) szervize valamint értékesítése.
Fejér-Fog Kft.
1118 Bp., Breznó köz 11. 06-1-788-5391
) info@fejerfog.hu, web: www.fejerfog.hu. A W&H magyarországi vevőszolgálata, márkaszervize Prémium Service minősítéssel és forgalmazója

Goldent Hungary Fogászati Alapanyaggyártó és Kereskedelmi Kft. 2120 Dunakeszi, Alagi majori út 3. +36 27 543 230 fax: +36 27 543 231
A Saeyang mikromotorok kizárólagos importőre és szervizelője valamint a Goldent műfogak gyártója.

Modent Fogászati Szerviz
1077 Budapest, Rózsa u. 29.
: 06-1-342-9348, mobil: 20/934-2986 (Diplomat Dental, Kavo, W&H, Bien Air, Ekom, NSK, MK-dent, EMS, Schick, Technodent, EuroC.A.D.)

MEDISERVIS – Czuczor s.r.o Konopná 2, 94064 Nové Zámky : +421-35-642-6353

) mediservis@mediservis.sk, www.mediservis.sk


CHIRANA Magyarországi kizárólagos képviselője, Simple&Smart, Ekom, Medilux, Bien Air, CLT, NARDI, Ledex, Kovonax – ülőkék, Woodpecker, LM-Amdent
Röntgen Kft.
6000 Kecskemét, Aradi vértanúk tere 5. ) rontgenkft.hu, info@rontgenkft.hu 76/482-250 vagy 30/9434-756

Kezelőegységek, panoráma- és intraorális röntgenek, röntgenfilm előhívók, autoklávok, hőlégek, kézidarabok, kompresszorok szervize, kereskedelme.
TELEMEDICA Szerviz Orvostechnikai, Műszaki, Kereskedelmi és Szolgáltató Kft.
3521 Miskolc, Pólya Jenő u. 26. :06-46/404-521, 06-20/974-6690
) telemedicaszerviz@gmail.com web: www.telemedicaszerviz.hu Kezelőegység, kézidarab, kompresszor, röntgen, elszívó, autokláv, sterilizátor, mennyezeti lámpa javítása és kereskedelme (Diplomat Dental, Kavo, Sirona, Finndent, W&H, A-dec, Bien Air, Planmeca)
Fogászati gyártók
BIONIKA Medline Kft.
3516 Miskolc, Tégla u. 29. 06-20-964-4146 www.bionika.hu, www.implantshop.hu ): info@bionika.hu
Implantátum rendszerek és beültető műszerek fejlesztése, gyártása, kereskedelme a fogászat, szájsebészet, traumatológia, ortopédia területén.
Gyógylézer Család Kft.
: 06-1/203-0001, 06-70/679-8810

) ugyfelszolgalat@gyogylezer.hu www.gyogylezer.hu
Orvosi diódalézerek 1989 óta: Gyártás és fejlesztésszerviz – kereskedelem – akkreditált továbbképzések
Kerox Kft.
2038 Sóskút, Kerox utca 1.
: +36 30 203 1204
PRECIZITÁS
Német mérnökök és fogászati szakemberek dolgoznak együtt, hogy tökéletes protetikai rendszert alkossanak.
): info@keroxdental.net, www.keroxdental.net Cirkónium alapanyag gyártása
Idő- és pénzmegtakarítás a fogtechnikusok és a fogorvosok számára.

18 Dental Tribune Hungary Edition | 2022/04
SZERVIZEK, GYÁRTÓK LISTÁJA
FOGÁSZATI
BIONIKA
hirdetés MEDENTIKA IMPLANTÁTUMOK MÁR MAGYARORSZÁGON IS ELÉRHETŐ IPS Magas Precizitású Implantációs RendszerInnovatív Komponensek GYORSASÁG Idő- és pénzmegtakarítás a fogtechnikusok és a fogorvosok számára. PRECIZITÁS Német mérnökök és fogászati szakemberek dolgoznak együtt, hogy tökéletes protetikai rendszert alkossanak. MADE IN GERMANY Tradicionálisan magas minőség. Medentika® ÉLETHOSSZIG TARTÓ GARANCIA PIACVEZETŐ MÁRKAKOMPATIBILIS GYÁRTÓ Az összes ismert implantátum rendszerrel kompatibilis. IMPLANTÁTUMOK MAGYARORSZÁGON IS ELÉRHETŐ Implantációs
RendszerGYORSASÁG
GERMANY Tradicionálisan minőség. ®aktinedeM ÉLETHOSSZIG TARTÓ ANCIARAG MÁRKAKOMPATIBILIS Az összes rendszerrel Medentia-3- hirdetés.indd 1 2021. 11. 26. 10:14
szervizek
Fogászati

A DIGITÁLIS SZABADSÁG VILÁGÁBAN!
segítséget a 6 lépésből álló Alpha Digital Workflow, amely az intraorál scanneléstől a kész fogmű behelyezéséig terjed. Ne zárja magát keretek közé, lépjen az Alpha Implant Kft.-vel a Digitális Szabadság Világába! 3D NYOMTATÓ REGIONÁLIS KÉPVISELŐ:















































IMPLANTÁTUM IRÁNYÍTOTT SEBÉSZET








































































INTRAORAL SCANNER CIRKON TÖMB




















ÜDVÖZÖLJÜK
A 10 éves Alpha Implant Kft. a hagyományos munkafolyamatok mellett a digitális workflow minden lépésére megoldást kínál. A digitális technika fejlődése a fogászati piacon is egyre nagyobb teret hódít. Ebben nyújt PROTETIKAI FELÉPÍTMÉNYEK +36 1 353 9090 | info@alphaimplant.hu | www.alphaimplant.hu